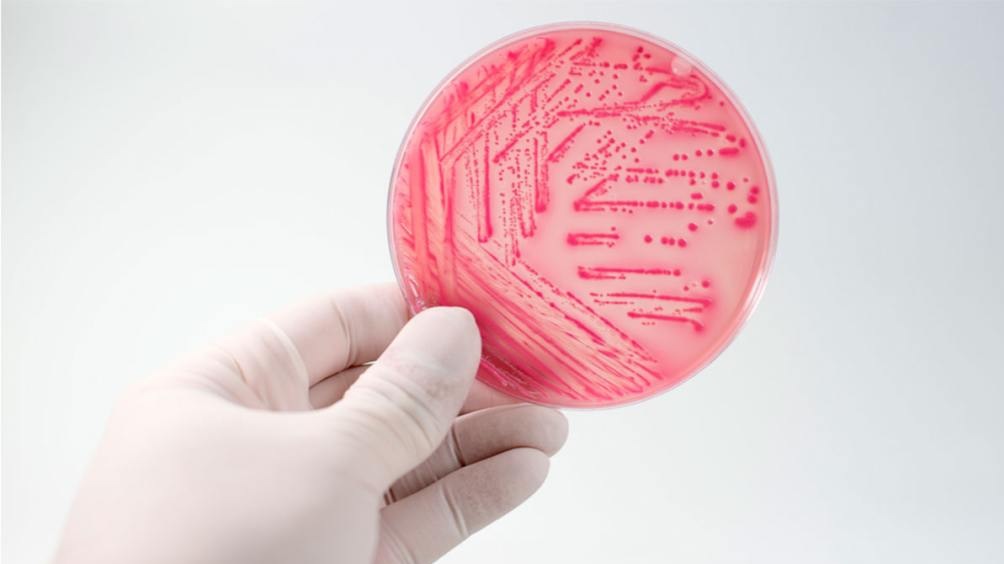

En este marco, es importante tener en cuenta varios aspectos sobre esta afección que, si bien es grave, se puede lograr una completa recuperación. Para saber qué es el SUH, se produce cuando los pequeños vasos sanguíneos de los riñones se dañan e inflaman.
Este daño puede provocar la formación de coágulos en los vasos sanguíneos que obstruyen el sistema de filtración de los riñones y provocan insuficiencia renal, lo que puede ser mortal en algunos casos.
Si bien cualquier persona puede padecer síndrome urémico hemolítico, esta afección es más frecuente en niños y su primer síntoma es la diarrea, que dura varios días y que a menudo presenta sangre. La causa más común de este síndrome es la infección con ciertas cepas de la bacteria Escherichia coli, que se encuentra en los intestinos de humanos y animales sanos. Además de producir diarrea, algunas cepas de esta bacteria producen una toxina llamada Shiga o STEC.
“Cuando una persona está infectada con una cepa de STEC, la toxina Shiga puede entrar en su torrente sanguíneo y puede causar daño en los vasos sanguíneos, lo cual puede provocar el síndrome urémico hemolítico, aunque la mayoría de las personas que están infectadas con E. coli, incluso con las cepas más peligrosas, no desarrollan síndrome urémico hemolítico”, relató la doctora Valeria El Haj (M.N. 99.291 y Directora Médica Nacional de OSPEDYC).
En cuanto a los síntomas que presenta el SUH, entre los más comunes se enumeran la diarrea -que a menudo es sanguinolenta-, dolor, cólicos o hinchazón en el abdomen, vómitos y fiebre. Todas las formas de síndrome urémico hemolítico, sin importar la causa, dañan los vasos sanguíneos y este daño hace que los glóbulos rojos se descompongan, se formen coágulos de sangre en los vasos sanguíneos y finalmente, se dañen los riñones.
Los signos de estos cambios incluyen palidez marcada, fatiga extrema, dificultad para respirar, tendencia a la formación de moretones, sangrado inusual, disminución de la cantidad de orina en la micción o sangre en la orina, hinchazón de piernas, pies o tobillos, y con menos frecuencia en cara, manos, pies o cuerpo entero, y confusión, convulsiones o ACV.
“Con relación a las personas propensas a contraer este síndrome, el riesgo de desarrollar síndrome urémico hemorrágico es mayor para los niños de 0 a 5 años, adultos mayores a 65 años, personas con sistemas inmunitarios debilitados o personas con ciertos cambios genéticos que las hacen más susceptibles al síndrome urémico hemorrágico”, agregó la facultativa, quien pidió estar alerta a los grupos de riesgo.
“Es por ello que estos estratos poblacionales deben tener un especial cuidado y evitar los factores de riesgo como comer carne o productos contaminados, nadar en piscinas o lagos contaminados con heces, o tener contacto cercano con una persona infectada, por ejemplo, con familiares o personas en un centro de cuidado infantil”, finalizó diciendo la profesional.
En pos de prevenir la llegada del SUH, los especialistas recomiendan medidas para protegerse contra la infección por E. coli y otras enfermedades transmitidas por alimentos: 1) No consumir leche, jugo ni bebidas sin pasteurizar, 2) Lavarse las manos antes de comer, después de ir al baño y tras cambiar pañales, 3) Limpiar utensilios y superficies donde se apoya la comida con frecuencia, 4) Cocinar la carne a una temperatura mínima de 160 grados, 5) Descongelar la carne en el microondas o en el refrigerador, 6) Separar alimentos crudos de alimentos listos para consumir. No colocar carne cocida en platos en los que antes haya habido carne cruda, 7) Colocar la carne debajo de productos ya elaborados en el refrigerador para evitar que caiga líquido en ellos, 8) No nadar en agua contaminada y 9) No meterse en piletas públicas o con gente si presentas diarrea.